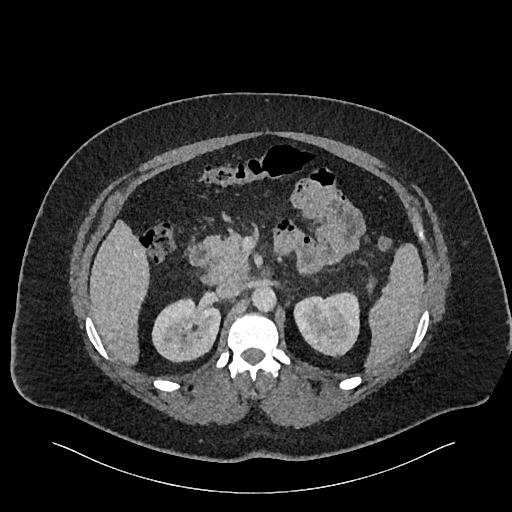
image 157
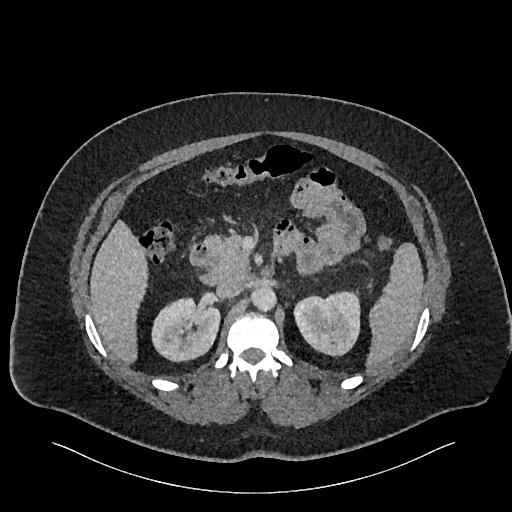
image 158
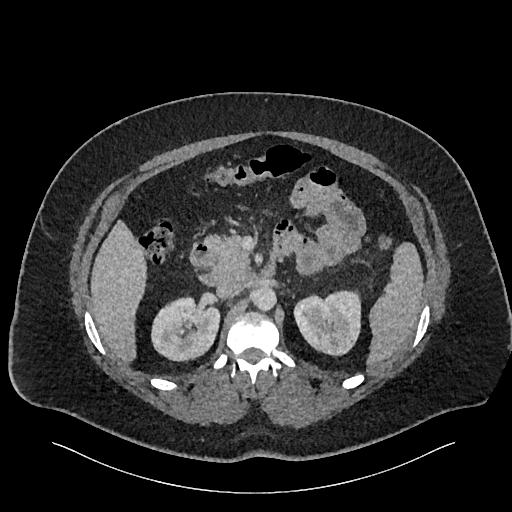
image 159

JiveX ReviewImage Report |
Image Series
This series contains the following 498 images: >> Back to report index Important Note: Any image data is available both as JPEG and DICOM format. To get to the JPEG images, please follow the related links (study / series) and directly click on the small preview images in the overview panel. Please remind that the JPEG images were compressed using lossy compression algorithms and thus are not approved for diagnosis or post processing of any other kind. For viewing the original DICOM images from the overview panel click on the images number accoringly. DICOM is short for "Digital Imaging and Communication in Medicine" and is an image format specific to medical imaging. Viewing DICOM images usually is not possible through "standard" image viewing software and requires a DICOM enabled viewing program installed on your computer. You can download the JiveX DICOM Viewer (Personal Edition) from the VISUS Health IT GmbH website. By the help of this program you can load, view and print DICOM images. Please read installation instructions and license agreements carefully. |
|